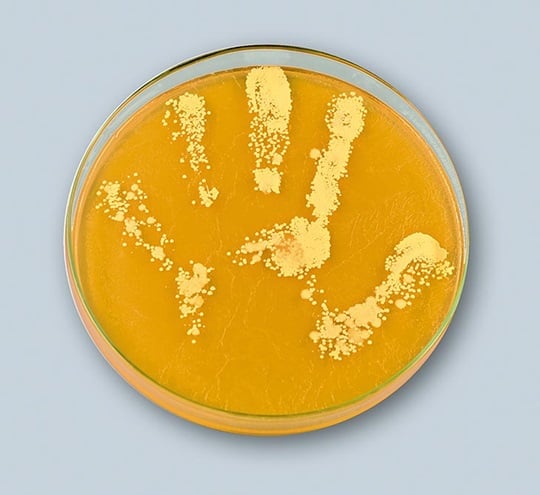
Contact-plate sampling

Internationale Aktionstage
Jährlich finden Aktionstage statt, die die Bedeutung von Reinigung und Desinfektion der Hände und Flächen im Gesundheitswesen betonen und Bewusstsein für Sepsis und Antibiotikaresistenzen schaffen. Erhalten Sie hier Informationen und Kampagnenmaterial zu ausgewählten Aktionstagen.
Mehr erfahren